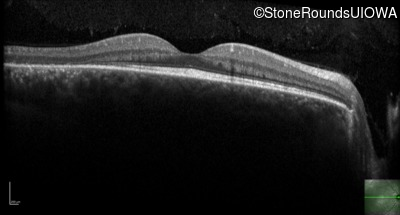
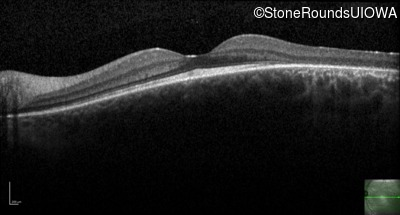
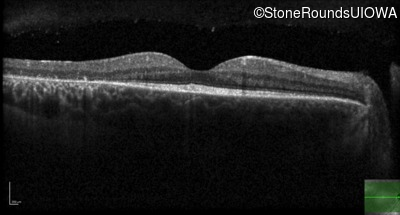
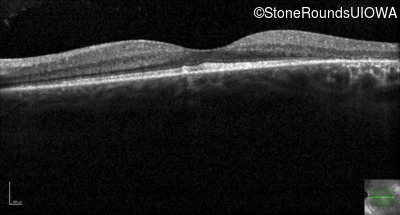

Case
SR1923
Student Mode
AD Retinitis Pigmentosa (IA1aii)
Male
Male
Hidden
SR1923
Student Mode
AD Retinitis Pigmentosa (IA1aii)
Male
Male
History
This 24 year old man has recently noticed that he sees more poorly than his peers in movie theaters.
| Age at visit: 26 years |
Diagnosis & molecular findings
| Disease | Gene | Allele 1 variant(s) | Allele 2 variant(s) | Inheritance mode |
|---|---|---|---|---|
| AD Retinitis Pigmentosa | PRPH2 | Pro216Ser CCT>TCT | AD |